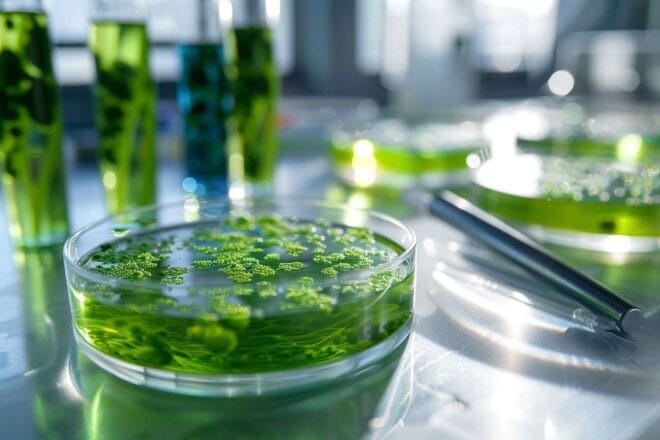

Europe’s Challenge to Capitalize on the Green Gold of Microalgae
Explore why the promising environmental solution of microalgae, often referred to as green gold, struggles to gain a significant foothold in Europe.
Microalgae: Europe’s Underexploited ‘Green Gold’
Microalgae are seen as the future’s ‘green gold’ with vast potential ranging from nutrition to cosmetics, celebrated for their versatility and rapid growth capabilities.
Despite their appeal, their use in Europe is still minimal. Why this paradox?
A More Favorable Climate in Asia
European microalgae production significantly trails behind that of Asian countries. The European Algae Biomass Association (EABA) reports that Europe produces only 650 tons of microalgae biomass annually, compared to 130,000 tons globally.
Asian countries excel in production, leveraging traditional consumption habits and a conducive climate, explains Maeva Subileau, a biotechnology professor at the Institut Agro de Montpellier.
Burdensome Regulatory Procedures
The strict European regulations, particularly the Novel Food regulation, require extensive testing to confirm the safety of non-traditionally consumed foods in the EU.
This lengthy and expensive process can cost up to one million euros. “Easing some regulations would facilitate the introduction of new microalgae species,” notes Hélène Marfaing from the Algae Study and Valorization Center.
Substantial Investments Required
Microalgae production demands significant investments, ranging from 370,000 euros to 800,000 euros for 100 hectares, whether for open-air or closed-loop systems. Fermentation cultivation, although pricier, yields more material per liter.
Despite these challenges, microalgae remain a promising resource. Their yield, versatility, and nutritional potential continue to attract interest across various sectors. The key question remains how Europe will overcome these barriers to fully leverage this ‘green gold’.